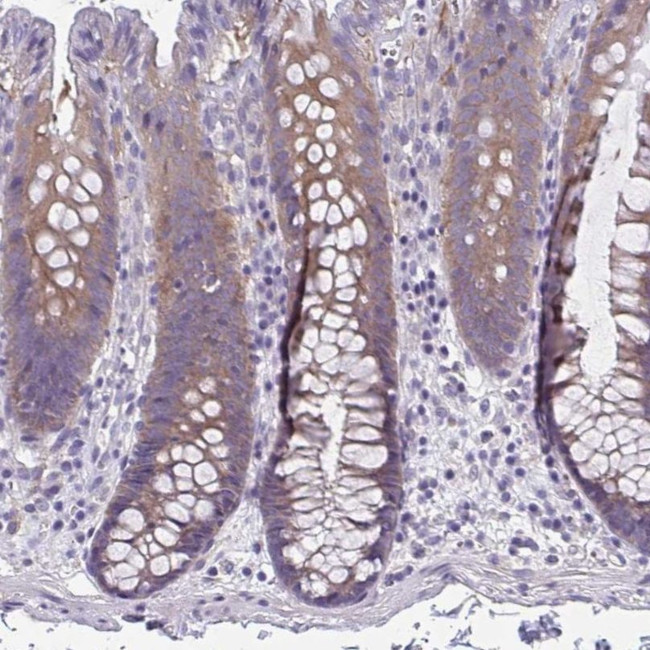
LPIN3 Antibody in Immunohistochemistry (IHC)

Search
Invitrogen
LPIN3 Polyclonal Antibody
{{$productOrderCtrl.translations['antibody.pdp.commerceCard.promotion.promotions']}}
{{$productOrderCtrl.translations['antibody.pdp.commerceCard.promotion.viewpromo']}}
{{$productOrderCtrl.translations['antibody.pdp.commerceCard.promotion.promocode']}}: {{promo.promoCode}} {{promo.promoTitle}} {{promo.promoDescription}}. {{$productOrderCtrl.translations['antibody.pdp.commerceCard.promotion.learnmore']}}

Please note: We are reviewing Western blot images included in the antibody testing data in our catalog, including those provided by third parties. Unless expressly labeled or annotated as “raw-unedited”, Western blot images included in the antibody testing data in our catalog may have been edited, optimized or otherwise adjusted for presentation.
产品信息
PA5-62663
种属反应
宿主/亚型
分类
类型
抗原
偶联物
形式
浓度
规格
纯化类型
保存液
内含物
保存条件
运输条件
RRID
产品详细信息
Immunogen sequence: FFVQELESDD EHVPPGLCTS PIPWGGLSGF PSDSQLGTAS EPEGLVMAGT ASTGRRKRRR RRKPKQKEDA VATDSSP
Highest antigen sequence identity to the following orthologs: Mouse - 73%, Rat - 75%.
靶标信息
Humans lipodystrophy is characterized by loss of body fat, fatty liver, hypertriglyceridemia, and insulin resistance. Mice carrying mutations in the fatty liver dystrophy gene have similar phenotypes. Through positional cloning, the mouse gene responsible for fatty liver dystrophy was isolated and designated Lpin1. The nuclear protein encoded by Lpin1 was named lipin. Lpin1 mRNA was expressed at high levels in adipose tissue and was induced during differentiation of preadipocytes. These results indicated that lipin is required for normal adipose tissue development and provided a candidate gene for human lipodystrophy. Through database searches, mouse and human EST and genomic sequences with similarities to Lpin1 were identified. These included two related mouse genes and three human homologs. Human LPIN1 gene has been mapped to 2p25.; linkages of fat mass and serum leptin levels to this same region have been noted. Human LPIN2 and LPIN3 mapped to chromosomes 18p11 and 20q11-q12, respectively. The mouse genes encoding Lpin1, Lpin2, and Lpin3 mapped to chromosome 12, 17, and 2, respectively.
仅用于科研。不用于诊断过程。未经明确授权不得转售。
篇参考文献 (0)
生物信息学
蛋白别名: dJ450M14.2; dJ450M14.3; dJ620E11.2; lipin 3-like; Lipin-3; Lipin-3-like; Phosphatidate phosphatase LPIN3; RP4-620E11.3
基因别名: LIPN3L; LPIN3
Entrez Gene ID: (Human) 64900